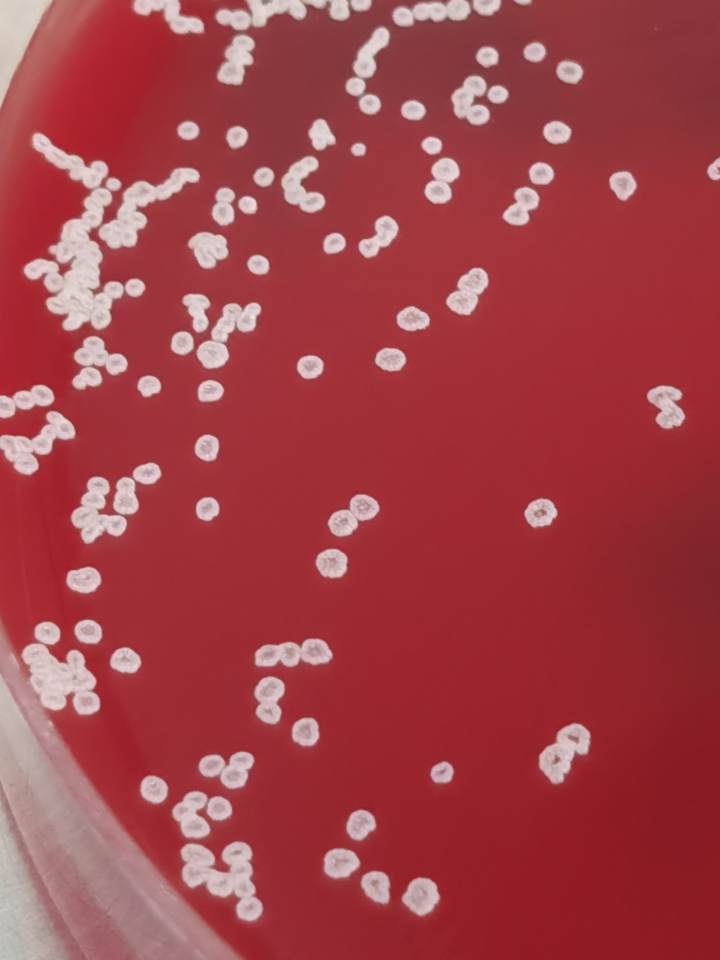
右腿比左腿整整粗一圈！爱穿*袜丝**的她遭遇罕见致病菌，差点连话都不会说

钱江晚报·小时新闻 通讯员 王文婷 记者 何丽娜
45岁的陈女士(化名)是个不折不扣的“*袜丝**控”,除寒冬腊月外,她常喜欢穿*袜丝**出行,露出纤细的双腿,相当吸睛。但这几个月,她却一反常态地收起*袜丝**,默默套上了牛仔裤,裹得严严实实。
原来,陈女士无意间发现右侧小腿上有个小伤口,起初她并没在意,没想到之后创面竟越来越大,直至整条小腿都出现了红肿现象,整整比左腿粗上一圈,觉得不对的陈女士自行去药房购药,却效果甚微。
几天后,陈女士又淋了一场雨,寒战发热,当地医院对她进行抗感染治疗,高烧症状持续了半个多月仍未消退。此外,家人还发现陈女士开始出现嗜睡症状,无论怎么喊都叫不醒。“总觉得头痛难忍,再后来竟发展到不能与人正常交流。”经多方打听,陈女士来到杭州市第一人民医院就诊。

图片来源:视觉中国
接诊医生回忆,收住入院时,陈女士体温已经高达40.7度,各项炎症指标明显升高,右下肢及背部均有皮肤感染结痂表现,询问病史后得知,陈女士因患有系统性红斑狼疮,需长期服用药物。此时,医生已有了初步判断。
医生在给予经验性用药后,同时对陈女士进行伤口的脓液培养,血液培养和腰穿抽取脑脊液后脑脊液培养及NGS(第二代高通量测序技术),经精心培养观察,终于在标本内发现了罕见存活的奴卡菌。通过针对病原菌的精准治疗,陈女士一周后已顺利出院。
市一医院检验科岑坷介绍,奴卡菌是隶属于放线菌属的革兰染色阳性的需氧菌,国内很少见。

奴卡菌广泛分布于自然环境中,如土壤,水,腐烂的植物和动物等,能经呼吸道、皮肤伤口入侵, 易经血行播散致全身,从而引起多器官的感染性疾病,也可引起罕见的脑脓肿。
奴卡菌不属于人体正常菌群,而是一种条件致病菌,主要引起外源性感染,好发于免疫功能缺陷的患者,相关医学研究数据表明:在奴卡菌造成的感染中,64%的患者存在免疫功能受损。
岑坷医生分析,陈女士之所以会感染这一疾病,可能跟她自身的免疫功能较低有关,“患有红斑狼疮需服药控制病情,长期处于免疫抑制状态,属于该病的易感人群”,之后通过外伤播散至颅内造成感染,才会出现相关神经系统症状。但对于免疫功能正常人群而言,奴卡菌的感染概率并不是很大,无需过度惊慌。
本文为钱江晚报原创作品,未经许可,禁止转载、复制、摘编、改写及进行网络传播等一切作品版权使用行为,否则本报将循司法途径追究侵权人的法律责任。